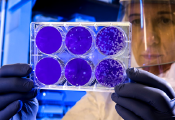

La Industria de la Iluminación representada por ANFALUM ha creado un nuevo grupo de trabajo para analizar las aplicaciones de la luz ultravioleta. Un tipo de iluminación que ha aparecido últimamente en la prensa diaria por su utilidad como desinfectante contra el Covid-19, pero que tiene consecuencias en la salud de los seres humanos.
La Organización Mundial de la Salud se ha mostrado tajante indicando que las lámparas ultravioletas sólo se pueden usar en lugares públicos vacíos. En este mismo sentido se manifestó el Consejo General de Enfermería de España, donde advierten del uso de esta iluminación sin medidas preventivas adecuadas, ya que puede provocar quemaduras, cáncer, daños a la córnea o a la percepción de los colores, etc.
El nuevo grupo de trabajo se crea con el fin de aprovechar las propiedades bactericidas de la iluminación UV-C, y frenar la falta de información precisa, sin argumentos científicos ni técnicos, unida a la falta de Especificaciones y Normas que garanticen la seguridad del uso de luz ultravioleta.
ANFALUM coordinará el grupo uniendo la voz de expertos de laboratorios de ensayos de España, de investigadores del ámbito universitario, junto a la experiencia y conocimientos de los fabricantes y a la Asociación Española de Normalización UNE; a los que se unen la Asociación de Fabricantes de Equipos de Climatización, AFEC. Todo el trabajo de equipo estará sometido al criterio de los Ministerios de Sanidad y de Industria, Comercio y Turismo, con los que se mantiene un contacto permanente.
Primera reunión para definir el plan de acción
El Grupo de Iluminación UV-C ya ha celebrado su primera reunión técnica, en la que se ha trazado un plan de acción que permita elaborar la especificación técnica basada en los siguientes ejes: analizar las características divergentes con las normas, tanto de lámparas como de luminarias, de otras tecnologías; y establecer las actuaciones necesarias para la instalación y uso correcto de la luz ultravioleta.
En suma, a través del nuevo grupo de trabajo de ANFALUM se va a impulsar el I+D con el que normalizar este tipo de tecnología UV-C para que sea efectiva con los gérmenes y virus sin que dañe a nuestras células. Sólo a través de grupos de trabajo con expertos en diversas disciplinas sentaremos las bases técnicas, de seguridad, calidad y buenas prácticas útiles para toda la cadena de valor.
Tal y como sostiene Alfredo Berges, director general de ANFALUM: “Estamos ante un tipo de luz que no sirve para iluminar, y que sólo un uso controlado permite higienizar el ambiente. A través del grupo de científicos, y de la experiencia de los fabricantes de iluminación, se podrán adelantar los avances que arrojen estas investigaciones. De este modo, evitaremos perjuicios a los seres humanos, eliminando del mercado los equipos que no cumplan los mínimos requisitos de seguridad”.

La asociación muestra su lado más técnico que potencie la desinfección de ambientes a través de la luz
La asociación muestra su lado más técnico que potencie la desinfección de ambientes a través de la luz







